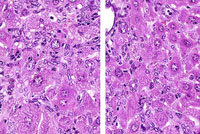
Bile duct cyst

The Digitized Atlas of Mouse Liver Lesions

Much of the work carried out by DTT is in support of the National Toxicology Program (NTP), an interagency partnership of the Food and Drug Administration, National Institute for Occupational Safety and Health, and NIEHS.
Visit the NTP WebsiteChronic active inflammation associated with an increased incidence of hepatocellular neoplasia has been described in mice with Helicobacter hepaticus infection. The hepatitis starts as a focal, non-suppurative inflammation and progresses to chronic active hepatitis with minimal evidence of hepatocellular necrosis. Hepatocytomegaly, oval cell hyperplasia, cholangitis, bile duct hyperplasia, and cellular pleomorphism are characteristic changes associated with this infection. Helical bacterial organisms can sometimes be demonstrated with the Warthin-Starry silver stain.
Diffuse proliferation of sinusoidal lining cells, hepatocytomegaly, and karyomegaly are evident in this liver.
Chronic active hepatitis with oval cell hyperplasia and hepatocytomegaly are characteristic of infection with Helicobacter hepaticus. In the trichrome stain, note pericellular fibrosis (right) versus the control (left).
In situ end labeled of an apoptotic cell. Terminal desoxyribosyl-transferase mediated dUTP end labeling stain.